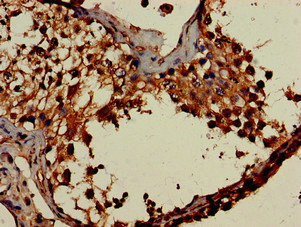

DOT1L Antibody
-
中文名稱:DOT1L兔多克隆抗體
-
貨號:CSB-PA848418LA01HU
-
規格:¥440
-
圖片:
-
Western Blot
Positive WB detected in: HepG2 whole cell lysate, A549 whole cell lysate
All lanes: DOT1L antibody at 3μg/ml
Secondary
Goat polyclonal to rabbit IgG at 1/50000 dilution
Predicted band size: 185, 165 kDa
Observed band size: 185 kDa -
Immunohistochemistry of paraffin-embedded human lung cancer using CSB-PA848418LA01HU at dilution of 1:100
-
Immunohistochemistry of paraffin-embedded human testis tissue using CSB-PA848418LA01HU at dilution of 1:100
-
-
其他:
產品詳情
-
產品名稱:Rabbit anti-Homo sapiens (Human) DOT1L Polyclonal antibody
-
Uniprot No.:
-
基因名:DOT1L
-
別名:Disrupter of telomere silencing protein 1 antibody; DOT 1 antibody; DOT1 antibody; DOT1 like antibody; DOT1 like histone H3 methyltransferase (S. cerevisiae) antibody; DOT1 like histone H3 methyltransferase antibody; DOT1 like histone H3K79 methyltransferase antibody; DOT1 like protein antibody; DOT1; S. cerevisiae; homolog of antibody; DOT1-like protein antibody; DOT1L antibody; DOT1L_HUMAN antibody; EC 2.1.1.43 antibody; H3 K79 HMTase antibody; H3 lysine-79 specific antibody; H3-K79-HMTase antibody; Histone H3 K79 methyltransferase antibody; Histone H3 methyltransferase antibody; Histone H3 methyltransferase DOT1-like antibody; Histone H3-K79 methyltransferase antibody; Histone lysine N methyltransferase H3 lysine 79 specific antibody; Histone methyltransferase DOT1L antibody; Histone-lysine N-methyltransferase antibody; KIAA1814 antibody; KMT4 antibody; Lysine N methyltransferase 4 antibody; Lysine N-methyltransferase 4 antibody
-
宿主:Rabbit
-
反應種屬:Human
-
免疫原:Recombinant Human Histone-lysine N-methyltransferase, H3 lysine-79 specific protein (331-484AA)
-
免疫原種屬:Homo sapiens (Human)
-
標記方式:Non-conjugated
本頁面中的產品,DOT1L Antibody (CSB-PA848418LA01HU),的標記方式是Non-conjugated。對于DOT1L Antibody,我們還提供其他標記。見下表:
-
克隆類型:Polyclonal
-
抗體亞型:IgG
-
純化方式:>95%, Protein G purified
-
濃度:It differs from different batches. Please contact us to confirm it.
-
保存緩沖液:Preservative: 0.03% Proclin 300
Constituents: 50% Glycerol, 0.01M PBS, pH 7.4 -
產品提供形式:Liquid
-
應用范圍:ELISA, WB, IHC
-
推薦稀釋比:
Application Recommended Dilution WB 1:500-1:5000 IHC 1:20-1:200 -
Protocols:
-
儲存條件:Upon receipt, store at -20°C or -80°C. Avoid repeated freeze.
-
貨期:Basically, we can dispatch the products out in 1-3 working days after receiving your orders. Delivery time maybe differs from different purchasing way or location, please kindly consult your local distributors for specific delivery time.
-
用途:For Research Use Only. Not for use in diagnostic or therapeutic procedures.
相關產品
靶點詳情
-
功能:Histone methyltransferase. Methylates 'Lys-79' of histone H3. Nucleosomes are preferred as substrate compared to free histones. Binds to DNA.
-
基因功能參考文獻:
- Each C-Nap1 ring at the proximal end of the two centrioles organizes a rootletin ring and, in addition, multiple rootletin/CEP68 fibers. PMID: 29463719
- Gene and protein expression of DOT1L was increased in synovial tissues of both osteoarthritis and rheumatoid arthritis patients. PMID: 29234911
- human mammary epithelial cells reprogramming is dependent on gene silencing by the DNA methyltransferase DNMT3A and loss of histone transcriptional marks following downregulation of the methyltransferase DOT1L. PMID: 28781076
- this study shows that Dot1l expression predicts adverse postoperative prognosis of patients with clear-cell renal cell carcinoma PMID: 27713173
- facilitates DNA damage repair; plays a protective role in ultraviolet radiation-induced melanomagenesis PMID: 29343685
- DOT1L cooperates with transcription factor ETS-1 to stimulate the expression of VEGFR2, thereby activating ERK1/2 and AKT signaling pathways and promoting angiogenesis. PMID: 27626484
- findings demonstrate that DOT1L over-expression has important clinical significance in ovarian cancer and also clarify that it drives cell cycle progression through transcriptional regulation of CDK6 and CCND3 through H3K79 methylation PMID: 28114995
- MLL-AF4 spreading gene expression is downregulated by inhibitors of the H3K79 methyltransferase DOT1L. PMID: 28076791
- our results identify DOT1L as a novel cofactor in N-Myc-mediated transcriptional activation of target genes and neuroblastoma oncogenesis. Furthermore, they characterize DOT1L inhibitors as novel anticancer agents against MYCN-amplified neuroblastoma. PMID: 28209620
- These results reveal a cooperative transcriptional activation mechanism of AEP and DOT1L and suggest a molecular rationale for the simultaneous inhibition of the MLL fusion-AF4 complex and DOT1L for more effective treatment of MLL-rearranged leukemia. PMID: 28394257
- this indicates that DOT1L function, like MLL, does not completely rely on its methyltransferase activity. Nevertheless, the small molecule DOT1L inhibition is sufficient to block the proliferation of MLL fusion-induced leukemia cells of murine and human origin PMID: 26923329
- DOT1L may play a critical role in DNMT3A-mutant leukemia. PMID: 27335278
- DOT1L, via dimethylated histone H3 K79, facilitates histone H4 acetylation, which in turn regulates the binding of BRD4 to chromatin in acute lymphoblastic leukemia. PMID: 27294782
- study demonstrates the development of potent DOT1L inhibitors with novel scaffolds PMID: 26914852
- these findings strongly support the contention that histone methyltransferase, DOT1L-associated epigenetic changes induced by HA play pivotal roles in miR-10 production leading to up-regulation of RhoGTPase and survival proteins. PMID: 27002147
- Report drug formulation/delivery of DOT1L inhibitor pinometostat in leukemia. PMID: 26385168
- MLL1 and DOT1L cooperate with meningioma-1 to induce acute myeloid leukemia. PMID: 26927674
- These data converge on a possible mechanism for hDot1L stimulation in which histone H2B physically 'corrals' the enzyme into a productive binding orientation. PMID: 26830124
- expression associated with poorer survival and aggressiveness of breast cancers PMID: 26199140
- analysis of a functional hotspot on ubiquitin that is required for the stimulation of human Dot1 PMID: 26240340
- Three candidate variants were identified: p.Glu1313Lys in Insulin receptor (INSR), p.Arg81Pro in F-box protein 24 (FBXO24) and p.Pro1146Leu in DOT1-like histone H3K79 methyltransferase PMID: 25576241
- The graded reduction of the DOT1L interaction with MLL-AF9 results in differential loss of H3K79me2 and me3 at MLL-AF9 target genes. PMID: 25921540
- The PZP domain of AF10 senses unmodified H3K27 to regulate DOT1L-mediated methylation of H3K79. PMID: 26439302
- Targeting DOT1L and HOX gene expression in MLL-rearranged leukemia and beyond. PMID: 26118503
- A genome-wide association study identifies PLCL2 and AP3D1-DOT1L-SF3A2 as new susceptibility loci for myocardial infarction in Japanese PMID: 24916648
- DOT1L rs12982744 G to C change and variant C genotype may contribute to knee OA risk in a Chinese Han population. PMID: 25005768
- inhibition of DOT1L, in combination with DNA damaging chemotherapy, represents a promising approach to improving outcomes for MLL-rearranged leukemia. PMID: 24858818
- Studies identified the evolutionarily conserved Af9 YEATS domain as a novel acetyllysine-binding module and established a direct link between histone acetylation and DOT1L-mediated H3K79 methylation in transcription control. PMID: 25417107
- Results provide evidence that transformation driven by MLL fusions as well as the recurrent AML-associated NUP98-NSD1 fusion oncogene is critically dependent on the ability of AF10 to stimulate DOT1L activity. PMID: 25464900
- Establishing the precise function of DOT1L in normal adult hematopoiesis and understanding its mode of action will aid in our understanding of the use of DOT1L as a therapeutic target in MLL-rearranged leukemia. PMID: 24854991
- DOT1L Regulates IL-22 Dependent Colon Cancer Stemness via H3K79 Methylation PMID: 24816405
- PITX2 forms complex with histone H3 lysine 4 (H3K4) methyltransferase. PITX2 complex methylates H3K4. PMID: 24486544
- Functional studies show that the mapped AF9/ENL interacting site is essential for immortalization by MLL-AF9, indicating that DOT1L interaction with MLL-AF9 and its recruitment are required for transformation by MLL-AF9. PMID: 23996074
- In male subjects, the rs12982744 polymorphism in DOT1L is associated with hip osteoarthritis. PMID: 23505243
- a functional interaction between hDOT1L and RNAPII targets hDOT1L and subsequent H3K79 methylations to actively transcribed genes. PMID: 23012353
- Data show that histone monoubiquitylation H2Aub did not influence histone methyltransferase Dot1L activity. PMID: 22619169
- These data are a further step to better understand the role of Wnt-signaling during chondrogenesis and cartilage homeostasis. DOT1L may represent a therapeutic target for osteoarthritis. PMID: 22566624
- These findings identify a novel role for Bat3 in regulating DOT1L function, which plays a critical role in DNA damage response. PMID: 22373577
- down-regulation of DOT1L-mediated H3K79 methylation disturbs proliferation of human cells PMID: 22190683
- a novel STAT1-DOT1L interaction that is required for the regulation JAK-STAT-inducible gene expression PMID: 22002246
- These data point to DOT1L as a potential therapeutic target in MLL-rearranged leukemia. PMID: 21741597
- This permitted structure-activity studies of ubiquitylated mononucleosomes that revealed plasticity in the mechanism of hDot1L stimulation and identified surfaces of ubiquitin important for activation. PMID: 20208522
- study describes for the first time the components of DotCom and links the specific regulation of H3K79 trimethylation by Dot1 and its associated factors to the Wnt/Wingless signaling pathway PMID: 20203130
- titration of the level of ubiquitylated histone H2B within the nucleosome revealed a 1:1 stoichiometry of Dot1L activation. PMID: 19799466
- mistargeting of hDOT1L to Hoxa9 plays an important role in MLL-AF10-mediated leukemogenesis PMID: 15851025
- Altered phosphorylation of histone-H3 is associated with hepatocarcinogenesis PMID: 17094487
- Identification of ENL-associated proteins by mass spectrometry revealed enzymes with a known role in transcriptional elongation: pTEFb and DOT1L. PMID: 17855633
- suggesting a widespread mechanism for parallel or sequential recruitment of DOT1L and MLL to genes in their normal "on" state PMID: 18285465
- demonstration, using chemically ubiquitylated H2B, of a direct stimulation of hDot1L-mediated intranucleosomal methylation of H3 K79 PMID: 18449190
- the CALM-AF10 fusion protein can also greatly reduce global H3K79 methylation in both human and murine leukemic cells by disrupting the AF10-mediated association of hDOT1L with chromatin PMID: 19443658
顯示更多
收起更多
-
亞細胞定位:Nucleus.
-
蛋白家族:Class I-like SAM-binding methyltransferase superfamily, DOT1 family
-
數據庫鏈接:
Most popular with customers
-
-
YWHAB Recombinant Monoclonal Antibody
Applications: ELISA, WB, IHC, IF, FC
Species Reactivity: Human, Mouse, Rat
-
Phospho-YAP1 (S127) Recombinant Monoclonal Antibody
Applications: ELISA, WB, IHC
Species Reactivity: Human
-
-
-
-
-